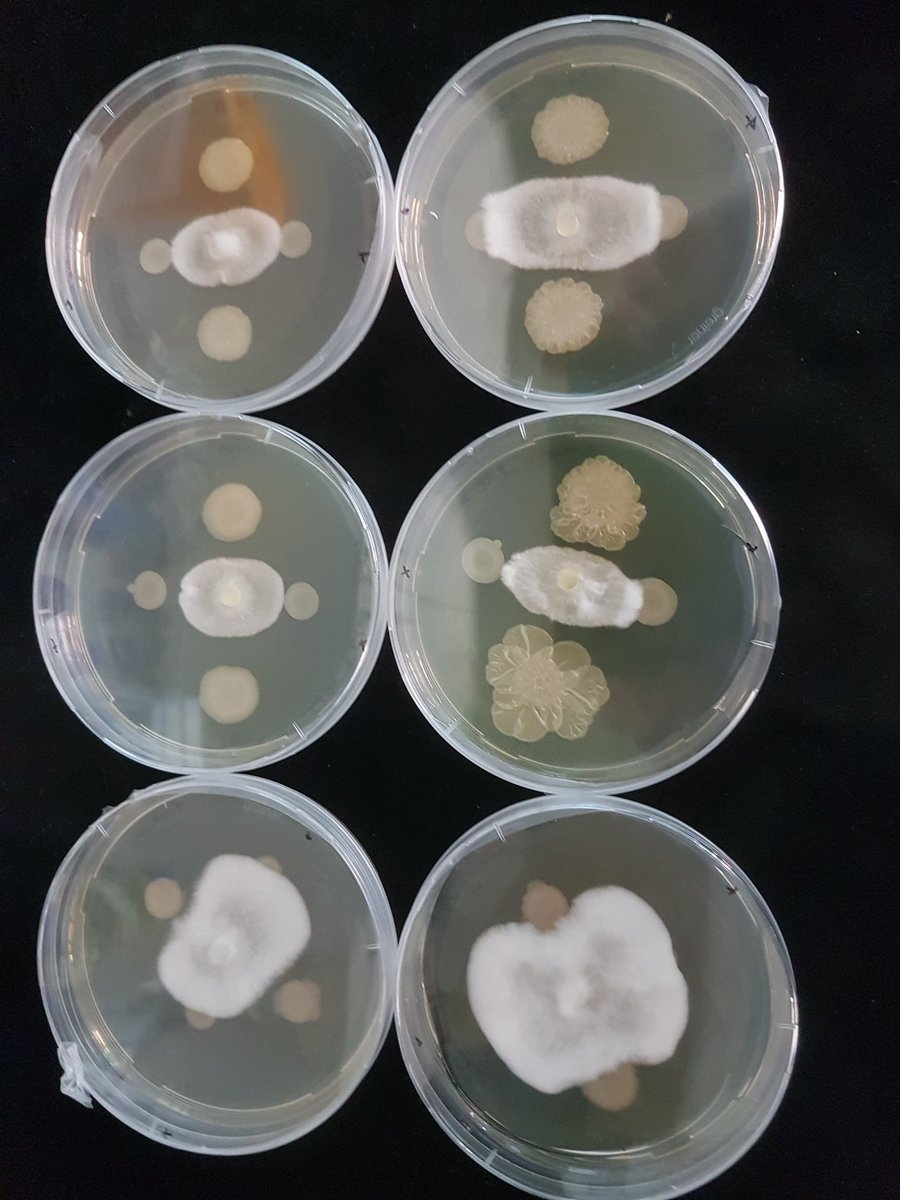
Microbial antagonism in full swing....lots of interesting interactions happening among microbiota members 😍 <a href="/Chavarroccx/">Edgar Chavarro</a> <a href="/myricae90/">Martina Cardoni</a>

Edgar Chavarro
@chavarroccx
Management trainee | Flower industry | Phytopathology
ID: 61199046
29-07-2009 13:52:49
200 Tweet
117 Followers
221 Following

Happy to sequence now bacteria SynCom together with Martina Cardoni at Team Thomma @teamthomma.bsky.social Universität zu Köln using Oxford Nanopore


One MinION is not enough Oxford Nanopore! Time to sequence Verticillium strains with our two MinIONs Team Thomma @teamthomma.bsky.social Universität zu Köln


Grow my babies grow 🦠🧫💓 40 bacteria strains growing from several days to make a Syncom...so exciting!!! #microbiology #fellinlovewithmicrobiology Universität zu Köln


And once the 🦠🧪🧫 babies grow ....time for some Oxford Nanopore 🧬sequencing by Martina Cardoni under the trusting supervision 👀of Edgar Chavarro ! 👌 💪😍


Excited for my first Oxford Nanopore 16S 🦠 sequencing guided by our expert Edgar Chavarro Team Thomma @teamthomma.bsky.social Universität zu Köln


Final coffee ☕️break goodbye 👋🏼to Martina Cardoni visiting us from Córdoba for the past months 🇪🇸.... Thanks 🙏🏼for the good work 💐 helping Wilko Punt & Edgar Chavarro! It was much fun having you around 💃🏼! Good luck 🤞🏼with thesis writing 🖥️and hope our paths cross again, soon 😊!


Microbial antagonism in full swing....lots of interesting interactions happening among microbiota members 😍 Edgar Chavarro Martina Cardoni

Happy to work together with Hanna Rovenich, we use Oxford Nanopore to sequence her first algae genome! Team Thomma @teamthomma.bsky.social Universität zu Köln


Excited to run for the first time 16S profiling of bacterial SynCom treated with different fungal AMPs 🥳Team Thomma @teamthomma.bsky.social Universität zu Köln using Oxford Nanopore, for this we used an old R9 flowcell and the 16S barcoding sequencing kit


We are looking for a motivated PhD student to join Team Thomma @teamthomma.bsky.social and work on fungal interactions with the microbiota, including micro-algae. Send me a DM if interested!



Look here! Result of our Team Thomma @teamthomma.bsky.social Easter egg hunt!biorxiv.org/content/10.110… Another collaboration with team Michael F Seidl, led by Edgar Chavarro with help from Nick Snelders David T Anton Kraege Wilko Punt and Twitter-less others. A 🧵 [1/14]

We’ve recently participated in the European Reference Genome Atlas European Reference Genome Atlas Earth BioGenome Project and I’m very excited that our genome assembly of the terrestrial microalga Coccomyxa viridis is now available on #bioRxiv doi.org/10.1101/2023.0…

My last week working in this beautiful group Team Thomma @teamthomma.bsky.social, and one last Oxford Nanopore run now doing some Pore-C! Natalie Schmitz Anton Kraege was a pleasure!


We are recruiting! 📣 One postdoc position available on a collaborative project Hubrecht Institute and NematologyWUR 📆 Start date: 1 March 2024. Location: Utrecht Science Park. Application: hubrecht.eu/job/postdoc-38… Expertise: next-gen sequencing, bioinformatics, or plant biology 🙏RT.

📣 First on bioRxiv >> 📰now published in PLOS Pathogens! Congratulations Edgar Chavarro et al. 🪇 journals.plos.org/plospathogens/… Michael F Seidl Wilko Punt Nick Snelders Anton Kraege David T

📣BIG day today: Edgar Chavarro will defend his PhD thesis Wageningen U&R today on effector proteins of the fungal soil-borne pathogens Verticillium and Rosellinia 👨🎓🍀💐


Last month marks a major milestone: Edgar Chavarro successfully defended his PhD on effector proteins of the fungal soil-borne pathogens Verticillium and Rosellinia Wageningen U&R with Michael F Seidl as co-supervisor


